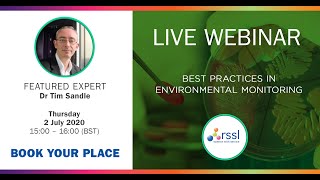
Webinar: Best Practices in Environmental Monitoring - Reviewing your Process for Compliance

Challenges in Counting Microbial Populations
Enroll to start learning
You’ve not yet enrolled in this course. Please enroll for free to listen to audio lessons, classroom podcasts and take practice test.
Interactive Audio Lesson
Listen to a student-teacher conversation explaining the topic in a relatable way.
Understanding Microbial Count Standards
🔒 Unlock Audio Lesson
Sign up and enroll to listen to this audio lesson

Alright, class! Let’s begin by discussing the standards for counting microorganisms. Can anyone tell me what unit is commonly used for expressing microbial counts in water samples?

Is it like 5 microorganisms per 100 ml?

Exactly, great job! These standards focus mainly on pathogens, particularly bacteria. Why do you think it’s important to monitor these microorganisms?

To ensure the water is safe to drink!

Correct! However, counting microorganisms isn’t straightforward. Looking at these small cells, which measure about 1 to 10 microns, can be challenging. What do you think we could do to visualize them?

Maybe use a microscope?

Exactly! Microscopes are vital tools here. But before we use them, we usually need to filter the water sample, which adds to the complexity. Keep that in mind as we move forward.
Culturing Method Explained
🔒 Unlock Audio Lesson
Sign up and enroll to listen to this audio lesson

Now, let's dive deeper into a common method called culturing. Can anyone describe how this method works?

You take a water sample and put it on a nutrient medium, right?

Yes! You take, say, 1 ml of the sample and place it on a nutrient medium, which supports bacterial growth. After incubating for 24 hours, what are we hoping to see?

Colony formations?

Exactly! Those clusters of bacteria we see are called Colony Forming Units or CFUs. Now, if the initial count was very high, what might happen to our colony counts?

If there are too many, it might be hard to count them, right?

That's spot on! In such cases, we commonly dilute the sample to ensure distinct colonies for counting.
Using Advanced Techniques
🔒 Unlock Audio Lesson
Sign up and enroll to listen to this audio lesson

Beyond culturing, there are advanced methods like flow cytometry. Who can explain what that is?

Isn't that where you pass cells through a channel and count them as they go?

Exactly! It's effective for counting cells quickly, but it raises issues of sample representativeness. Can anyone think of a potential downside?

If the sample isn't mixed well, it might not represent the whole population?

Right again! Sampling methods are crucial in microbial analysis. Additionally, sometimes we use staining methods to identify different types of microorganisms. What technique can we use for that?

Using dyes, right?

Exactly! Stains help differentiate between types of organisms, especially when viewed under a fluorescence microscope.
Understanding Viability of Microorganisms
🔒 Unlock Audio Lesson
Sign up and enroll to listen to this audio lesson

Lastly, let’s consider why identifying viable microorganisms is significant. Why does it matter if a microorganism is viable or non-viable?

Viable means they can grow and potentially cause harm, right?

Absolutely! Non-viable microorganisms won’t pose the same risk. Generally, pathogenic concerns primarily arise from viable cells. Recognizing this helps prioritize water safety measures.

And could turbidity indicate the presence of microorganisms?

That's correct! However, turbidity is not always conclusive for microbial presence. It’s essential to perform growth tests to truly understand what’s in the water.

So, we need both turbidity measurements and culture tests for accurate analysis?

Exactly! It’s this combination that gives us a complete picture of water quality.
Introduction & Overview
Read summaries of the section's main ideas at different levels of detail.
Quick Overview
Standard
Counting microbial populations is critical for assessing water quality, particularly concerning pathogens. This section highlights the challenges faced, such as the small size of microorganisms, the need for microscopy, and the use of culturing methods to grow colonies for visibility. It further elaborates on alternative techniques, including flow cytometry and staining methods, while emphasizing the importance of viable microorganisms in understanding potential health risks.
Detailed
In water quality monitoring, quantifying microbial populations, especially pathogens like bacteria, poses numerous challenges. The standard practice for analyzing microorganisms often involves determining concentrations expressed in units like 5 microorganisms per 100 ml. However, because bacteria range from 1 to 10 microns in size, visual counting requires filtration and microscopy, complicating direct measurement. A prevalent method used is culturing, where water samples are placed on nutrient mediums to allow bacteria to grow into visible colonies called Colony Forming Units (CFU). This process typically takes 24 hours, delaying results. Methods like flow cytometry offer advancements by counting cells as they pass through a channel, yet concerns about sample representativeness remain. Other techniques, such as using dyes to stain cells for detection, can assist in identifying specific bacteria. Ultimately, while turbidity serves as one measure of microbial presence, confirming viability through growth is essential for risk assessment.
Youtube Videos

Audio Book
Dive deep into the subject with an immersive audiobook experience.
Introduction to Counting Microorganisms
Chapter 1 of 7
🔒 Unlock Audio Chapter
Sign up and enroll to access the full audio experience
Chapter Content
So, this is a big challenge, counting microbial populations is a big challenge. One of the old standard methods is that people use what is called as a culturing method. A lot of people work on these various ways of doing it, but one of the simplest methods is to take a water sample and you culture the bacteria on a nutrient medium.
Detailed Explanation
Counting microbial populations, particularly in water, presents significant challenges because microorganisms are small and often not visible to the naked eye. One traditional method employed is culturing, which involves taking a water sample and introducing it to a nutrient medium that supports bacterial growth. The sample is then incubated, allowing bacteria to reproduce, which makes them visible as colonies. This process is time-consuming and requires careful handling to obtain accurate counts.
Examples & Analogies
Imagine trying to count a large number of tiny ants in a garden. It would be nearly impossible to see each individual ant unless they grouped together. Similarly, culturing helps microorganisms multiply so they can be counted, much like how waiting for the ants to swarm into a pile makes counting easier.
Culturing Process
Chapter 2 of 7
🔒 Unlock Audio Chapter
Sign up and enroll to access the full audio experience
Chapter Content
Typically, what you do is, you take a plate filled with some nutrients. There are some standard nutrients. Nutrient is something in which the bacteria will grow, uses that as a substrate and it will multiply.
Detailed Explanation
When culturing bacteria, researchers use nutrient-rich media that provides the essential materials required for bacteria to grow. This media acts like food for the bacteria, supplying energy and nutrients, which enables them to reproduce. For instance, if a researcher adds 1 ml of a water sample containing bacteria to this nutrient medium, after incubation, the bacteria will proliferate, creating visible colonies.
Examples & Analogies
Think of a baker adding yeast to dough. The yeast needs sugar (nutrients) to grow and multiply, resulting in a fluffy loaf of bread. Similarly, bacteria grow and multiply on nutrient media, forming visible colonies.
Observation and Enumeration
Chapter 3 of 7
🔒 Unlock Audio Chapter
Sign up and enroll to access the full audio experience
Chapter Content
So, when it becomes big you can see it. So, you have formation of a colony, one bacterial cell will multiply 2, 4, 6, 8 it multiplies in some fashion and whatever was this one single dot you cannot see now has become a colony.
Detailed Explanation
After incubating the sample, tiny bacterial cells multiply exponentially, leading to the growth of colonies that are large enough to see with the naked eye or under a microscope. Each colony originates from a single bacterial cell, which divides repeatedly, forming numerous cells in a cluster. This aggregation forms a colony that can be counted, referring to the concept of Colony Forming Units (CFUs).
Examples & Analogies
Think of planting a single seed in a garden. If nurtured under the right conditions, that one seed can grow into a large bush. Similarly, one bacterial cell can grow into a visible colony, allowing scientists to estimate the number of microbes present in the sample.
Challenges with High Concentrations
Chapter 4 of 7
🔒 Unlock Audio Chapter
Sign up and enroll to access the full audio experience
Chapter Content
So, what if it has 100 already? If you have 100, you have no problem because there are other methods of doing it. But if you do culturing when you have very high concentration is you already have a lot of dots and this at the end of one day, you may get the big jumble, a big mass and you cannot differentiate how many originally were there.
Detailed Explanation
When microbial populations are very dense, as in cases where there may be 100 or more microorganisms, the resulting colonies can merge into a single mass after incubation. This makes it challenging to count individual colonies accurately since they overlap, and researchers cannot easily differentiate between them. To address this issue, samples are often diluted before culturing to achieve a manageable concentration, allowing for distinct colony counts.
Examples & Analogies
Imagine trying to count jelly beans in a jar that's too full—the candies start to pile on top of one another, making it difficult to tell how many are present. By pouring out some jelly beans to create space, you could count them more accurately. Similarly, diluting samples helps researchers count colonies effectively.
Flow Cytometry as an Alternative
Chapter 5 of 7
🔒 Unlock Audio Chapter
Sign up and enroll to access the full audio experience
Chapter Content
So, microbes are treated like particles, so you can also look at it like a particle and look at it in a microscope and there are a lot of instruments now available, which use microscopy in order to count bacterial cells.
Detailed Explanation
In addition to culturing, flow cytometry is an advanced technique that allows for the counting of microbial populations. This process treats microbes as particles that can be analyzed individually. A water sample is passed through a small channel, and as each bacterium passes, it is counted. This method is gaining popularity because it can provide rapid results compared to traditional culturing, although it is not yet the standard method due to issues like sample representativeness.
Examples & Analogies
Imagine a supermarket checkout line with shoppers moving through quickly. A scanner counts each individual as they pass through the checkout. In the same way, flow cytometry counts bacteria as they flow through a small channel, quickly providing data on the total population.
Dye Staining for Identification
Chapter 6 of 7
🔒 Unlock Audio Chapter
Sign up and enroll to access the full audio experience
Chapter Content
So, people use other ways of detecting bacteria also which includes putting a dye something called a staining. They put a dye, this dye will go and absorb on different organisms in order to distinguish between which bacteria which fungus it is.
Detailed Explanation
Dye staining is another technique used to identify and differentiate between types of microorganisms. By applying specific dyes, researchers can highlight certain organisms, making it easier to distinguish between bacteria and fungi. This method is especially useful when paired with fluorescence microscopy, allowing scientists to visualize and count specific types of microorganisms effectively.
Examples & Analogies
Consider how artists use different colors of paint to create distinct sections in their artwork. Similarly, using different dyes helps scientists 'color code' and identify various microorganisms under a microscope, making the analysis more straightforward.
Importance of Viable vs. Non-Viable Counts
Chapter 7 of 7
🔒 Unlock Audio Chapter
Sign up and enroll to access the full audio experience
Chapter Content
The dead cell will not grow you like organic matter organic carbon it constitutes in that fraction it will not grow and it will not cause probably much harm as much harm as a pathogen will because when generally people are worried about microorganisms.
Detailed Explanation
Understanding the difference between viable and non-viable microorganisms is critical in microbial analysis. Viable microorganisms are alive and can grow, potentially causing harm or infections, while non-viable microorganisms are dead and do not pose the same risk. This distinction helps researchers prioritize their analysis and focus on the organisms that can impact health or environmental safety.
Examples & Analogies
Think of live plants and dead leaves in your garden. Live plants continue to grow and flourish, while dead leaves simply decay without affecting the living plants around them. Similarly, viable microbes are active and can cause issues, while non-viable microbes are essentially inactive.
Key Concepts
-
Microbial Counting Standards: Standards guide the analysis of microbial concentrations in water.
-
Culturing Methods: Culturing allows for the growth of microorganisms into visible colonies, called CFUs.
-
Viability vs. Non-viability: Understanding the difference between viable (living) and non-viable (dead) microorganisms is crucial for assessing risk.
-
Turbidity as an Indicator: Turbidity can signal high microbial presence but is not definitive.
-
Flow Cytometry Technology: This innovative method offers a rapid assessment of cell populations.
Examples & Applications
When testing water quality, a sample showing high turbidity might prompt further examination of microbial populations to assess safety.
Using a dilution factor enables researchers to estimate high bacterial counts accurately.
Memory Aids
Interactive tools to help you remember key concepts
Rhymes
When measuring bugs that we can't see, CFU is the key to clarity!
Stories
Imagine you're a scientist fishing for tiny bacteria in a big pond. You can’t see them, but by using a net of culture, you grow visible colonies like flowers sprouting from seeds!
Memory Tools
To remember CFU, think: Counted Found Units!
Acronyms
To recall the steps in culturing, remember
Sample - Pour - Incubate - Count.
Flash Cards
Glossary
- CFU (Colony Forming Unit)
A unit used to estimate the number of viable microorganisms in a sample, representing a colony that can form from a single organism.
- Viable
Referring to microorganisms that are alive and capable of growth.
- Nonviable
Microorganisms that are dead and incapable of growth.
- Turbidity
The cloudiness or haziness of a fluid caused by large numbers of individual particles, often indicating microbial presence.
- Flow Cytometry
A technique that allows for the counting and sorting of cells as they flow in a stream past a detector.
- Filtration
The process of separating suspended particles from a fluid by passing it through a filter.
- Nutrient Medium
A solid or liquid substance that provides the necessary nutrients for microbial growth.
Reference links
Supplementary resources to enhance your learning experience.
